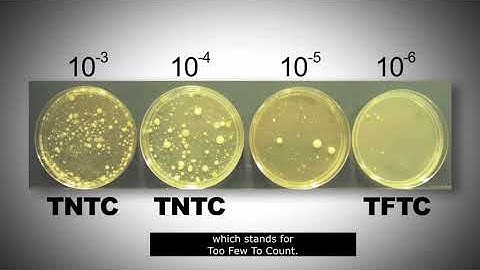
Standard plate count

⬇ DOWNLOAD NOW
Kalau muncul iklan pop-up, tutup lalu klik tombol kembali
Download lagu AEM 341 Lab 7 pour plating and bacterial calculation secara gratis hanya untuk keperluan promosi. Dukung artis favorit kamu dengan membeli musik original di iTunes atau platform resmi lainnya.
 AEM 341 Exam 1 Lecture 7 Bacterial Medium
AEM 341 Exam 1 Lecture 7 Bacterial Medium
 Total Plate Count (Total Aerobic Bacterial Count)_A Complete Procedure (BAM, Ch-3)
Total Plate Count (Total Aerobic Bacterial Count)_A Complete Procedure (BAM, Ch-3)
 How to Calculate CFU per ml of Bacterial Sample? in 3 Steps || cfu/ml in Microbiology
How to Calculate CFU per ml of Bacterial Sample? in 3 Steps || cfu/ml in Microbiology
 Pour Plate Technique for Colony Counting_A Complete Procedure (Microbiology)
Pour Plate Technique for Colony Counting_A Complete Procedure (Microbiology)
Standard plate count
Standard plate count
 AEM 341 L Lab 18 Microbial analysis for pond water and food products
AEM 341 L Lab 18 Microbial analysis for pond water and food products
 Isolation techniques | Pour plate method
Isolation techniques | Pour plate method
 Serial Dilution and Plate Counts
Serial Dilution and Plate Counts